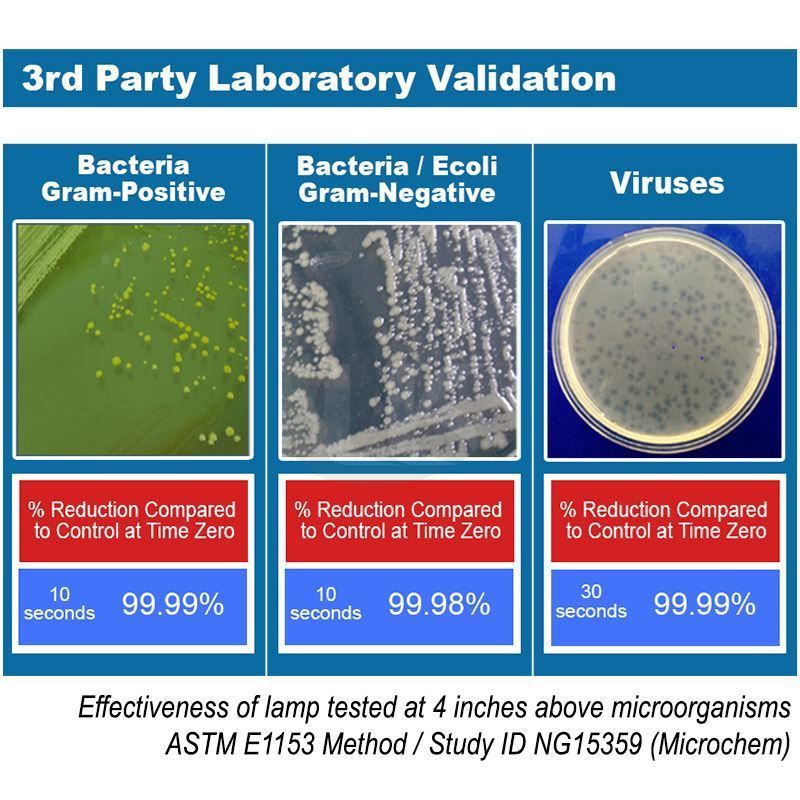

A
- Adapter[어댑터]
- Ampule[앰플]
- Anemometer[풍속계]
- Apparel[어패럴]
- Applicator[어플리케이터]
- Arsine[비소 발생 장치]
- Aspirator[아스피레이터]
- Autoclave[멸균기]
B
- Ball[볼, 비드]
- Barometers / Forecast[기압계]
- Basket[바구니]
- Baths[배스]
- Beakers, Glass / Quartz[비이커]
- Blender[분쇄기]
- Boat[보트]
- Bottles[각종 병]
- Bowl[(보울)]
- Box[박스]
- Brush[세척솔]
- Bucket and Bowl[버킷]
- Buret[뷰렛]
- Burner[버너]
C
- Chamber[챔버]
- Chromatography[크로마토그래피]
- Chromatography Analytical Instruments[크로마토그래피 검출기]
- Clamp & Support[클램프 및 지지대]
- Clean Bench[클린벤치]
- Cleaner & Detergent[세척/세정제]
- Cleaner&Clean Room[청소 및 클린룸]
- Colorimeter[색채계[비색계]]
- Condenser[콘덴서]
- Conductivity[전도도]
- Connector[커넥터]
- Container[용기]
- Cork Borer[콕크 보러]
- Counter[계수기]
- Crucible[도가니]
- Cryogenic[극저온 관련]
- Cutter[커터]
- Cylinder[실린더]
D
- Density Meter [비중계]
- Desiccant[흡습]
- Desiccator[데시케이터]
- Dish[디쉬]
- Dispenser[분주기]
- Distillation[증류]
- DO Meter[용존산소측정기]
- Dryer[건조기]
E
F
- Filter Paper[여과지]
- Filter, Capsule[캡슐 필터]
- Filter, Membrane[멤브레인 필터]
- Filter, Syringe[시린지 필터]
- Filter, Thimble[원통여과지]
- Filtration[여과]
- Filtration Device[여과장치]
- Filtration Device, 25, 47 & 90mm[사이즈별 여과장치]
- Flask[플라스크]
- Flowmeter[유량계]
- Forcep[집게]
- FT-IR[푸리에변환적외분광법]
- Funnel[깔때기]
- Furnace[전기로]
- Furniture[가구]
- Furnitures for Cleanroom[클린룸용 가구]
- Rotameter/Flow Controller[유량조절기]
G
H
- Heating[가열기]
- Haematology[혈액분석]
- Histology[조직학]
- Homogenizer[분쇄기]
- Hood[후드]
- Hotplate[가열판]
- Hotplate Stirrer[가열 교반기]
- Hotplate / Hotplate Stirrer Accessories[핫플레이트 악세사리]
- Hydrometer[비중계]
- Hygrometer[습도계]
- Hybridization[하이브리디제이션]
I
- Ice Box[아이스박스]
- Ice Maker[제빙기]
- Imhoff Sedimentation System[임호프콘 퇴적 시스템]
- Incubating[배양]
- Incubator[배양기]
J
L
M
N
O
P
- PCR Thermal Cycler[유전자 증폭기]
- pH Meter[PH 측정기]
- Pipet[피펫]
- Pipetter[피펫터]
- Plate[판]
- Polarimeter[편광계]
- Pressure[압력용기]
- Pump[펌프]
R
S
- Safety Cabinet[안전캐비넷]
- Safety Can[폐액통]
- Safety Container[안전용기]
- Safety Ear[청력보호용품]
- Safety Eye[시력보호용품]
- Safety Mask[안면보호용품]
- Safety Shield[안전차단막]
- Safety Shoe[안전화]
- Sampler[표본채집기]
- Scissor[가위]
- Shaker[쉐이커]
- Sieve[망체]
- Spatula & Spoon[스푼]
- Spectrophotometer[분광 광도계]
- Spectrophotometer Cell[광학 셀]
- Stir Bar[자력 교반 바]
- Stirrer Magnetic[자력 교반기]
- Stirrer Overhead[오버헤드 교반기]
- Stopcock[마개형 꼭지]
- Stopper[마개]
- Stopwatch / Timer[초시계 및 타이머]
- Sublimation[순화]
- Syringe[주사기]
T
- Tachometer[회전 속도계]
- Tape[테이프]
- Thermo - Hygrograph[온,습도]
- Thermometer[온도계]
- Tissue Grinder[세포 분쇄기]
- Titrator[적정기]
- Tong[집게]
- Tool[공구]
- Tray[트레이]
- Trays, Chip[칩트레이]
- Tube[튜브]
- Tubing[호스]
- Tweezer, Ideal-Tek[트위져-ideal Tek]
- Tweezer, PFA, Entegris[테프론 트위져-Entegris]
- Tweezer, Rubis[트위져-Rubis]
- Tweezer, Sipel[트위져-Sipel]
- Tweezer, Vacuum[진공 트위져]
U
V
W
- Wafer[웨이퍼]
- Wafer Handling[웨이퍼 취급]
- Washer[세척]
- Watch Glass[시계 유리]
- Water Purification[정수]
- Wiper[와이퍼]
- Wool[솜]/Wrapping(랩핑)
Z

.jpg)
.jpg)








